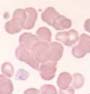

Definition:
Im Gegensatz zur Geldrollenbildung, bei der die Erythrozyten in Reihen liegen, ordnen sich die Erythrozyten bei der Agglutination in amorphen Klumpen an. Das Phänomen beobachtet man hauptsächlich beim Auftreten von Kälteagglutininen. Wird das Blut vor dem Ausstrich auf 37°C erwärmt, verschwinden die Agglutinate im Blutausstrich in den meisten Fällen. Auch das falsch hohe MCHC, das bei Kälteagglutininen in der maschinellen Messung oft beobachtet wird, normalisiert sich nach Erwärmen.
Vorkommen: